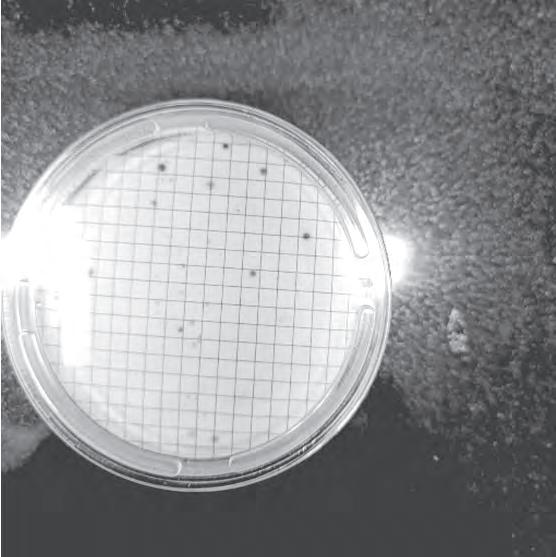

A B S T R A C T
Los ríos han sido un determinante para el asentamiento de las poblaciones sedentarias en el territorio que hoy conocemos como Bogotá. Desde lo Muiscas y su relación con el río Bogotá, siendo un pueblo eminentemente agrícola como base de su ali mentación y de su economía. Hasta la fundación de Bogotá, atravesada por el río Vicachá y San Agustín, son la razón por la cual la ciudad está en este territorio. Igualmente, fueron usados como fuente de energía mecánica para molinos de trigo, lavado de ropas y, lamentablemente, como vertedero de basuras y desechos.
Este proyecto busca generar un diálogo sobre la relación actual del cuerpo y el agua, generar consciencia del estado del agua que se encuentra en el espacio público y su privat ización, como se ven afectadas las personas que tienen necesi dades cotidianas que no tienen acceso al agua y deben hacer uso del agua que está en el espacio público


Privatización del agua y su potabilidad

1
Según ley de ministerio, el acceso al agua de dominio público sin permisos se permite si este se limita para las actividades de beber, bañarse y lavar ropa con el agua. Suena pertinente estas leyes cuando no se esta tomando en cuenta que las aguas de dominio publico no requieren ciertos fil tros de limpieza como el agua de dominio privado; es decir, el agua que se permite consumir no cumple con mínimos requisitos de potabilidad según la OMS. Por otro lado, haciendo caso omiso a los derechos de agua y salud, también esta el derecho a la privacidad y seguridad. El acto de bañarse es sin duda, uno de los momentos más íntimos y vulnerables para una perso na. Realizar cualquiera de estas activi dades permitidas en cuerpos de agua en los espacios públicos de la ciudad genera un escenario de precariedad que ocasiona desprecio y discriminación.
El problema, asimismo, recae en rol del ciudadano activo. Como todos tienen acceso al agua, los canales que cruzan zonas muy transmitidas y comerciales como el eje ambiental, el agua se enfrenta a las malas conductas de los ciudadanos como la mala deposición de basura que otros usan para bañarse y que luego van al sistema de acueductos viejos de Bogotá. Esto implica con problema de salud pública por contami nación.
El río ha sido fuente hídrica para Bogotá en diferentes momentos. A través de la historia su significado y uso ha sido diverso, pasó de tener gran relevancia para la ciudad y ser la fuente de agua del principal acueducto colonial, a ser un problema de salud pública por su contami nación. Si no somos capaces de garantizar los derechos del río Vicachá en pleno centro de Bogotá, núcleo educativo y político del país. Las universidades del centro, la comunidad y la Alcaldía podrían crear esfuerzos para revivir el río Vicachá, también conocido con los motes de Eje Ambiental, Avenida Jiménez, o río San Francisco.
Por lo que, en este trabajo es pertinente abordar una necesidad real de una población invisibilizada. El agua es una necesidad fundamental del ser humano y quienes no tienen acceso a esta se ven vulnerados y obligados a suplir su necesi dad con su entorno inmediato, en este entorno la condición del agua no es buena, no es potable e incluso puede trasmitir enfermedades, así como los entornos donde se encuentra son de carácter público mien tras que las actividades ligadas a esta son intimas, sin embargo, muchas de estas personas no lo saben.
Ministerio ambiental 1
Uso y Aprovechamiento.
Campo de acción

2
El San Francisco o Vicachá es un curso fluvial. Este marcaba el límite norte de la Bogotá en sus años de fundación colonial. Nace en el páramo de Cruz Verde1 y baja desde el cerro de Monserrate. Al llegar a la ciudad es canalizado. En la actual avenida Jiménez con calle Sexta confluye por debajo de la tierra con el río San Agustín.

Por medio de la herramienta del mapeo se busca entender los límites territoriales que componen el recorrido del río, su zona predial, UPZ, ZMPA, área protegida, etc., y los actores que lo intervienen.
Dentro del mapeo realizado se identifica la zona entre el nacimiento del rio y el centro de Bogotá. Es espacio escogido pre senta unas dinámicas muy interesantes que implica el alto movimiento comercial y labor alrededor del eje ambiental. Se garantizan unas interacciones de distintas dinámicas sociales que interceden con el agua, de forma directa e indirecta. Se pueden identificar dentro de cierto recor rido del rio, puntos que han sido domina dos más por la comunidad universitaria pero a medida que baja el rio en dirección sur, este dinamismo se empieza a perder.
Objetivos
- Buscar resolución a través de actos simbólicos que generen impacto y concientización en la zona afectada por el mal uso del espacio.
- Exponer a través de un tendero la necesidad no suplida de muchas personas respecto al acceso al agua y las activi dades limitadas que se realizan en este espacio.
- Sociabilizar el estado actual del agua en el eje ambiental y sus actores princi pales contaminantes.
- Cuestionar la calidad de vida a los alrededores del eje ambiental, es decir es este un lugar salubre para vivir dada su cercanía al eje.
- Entender las diferentes condiciones espaciales del lugar con respecto a los actores, actividades y usos diarios.
- Sociabilizar con los estudiantes de la zona, conocer sus perspectivas del lugar y cuestionar su interés y acercamiento con el eje ambiental.
Aguas de Dominio Público
Uso y Aprovechamiento.
Según el ministerio de ambiente, las aguas de dominio publico son aquellas que ocur ren por cauces artificiales derivadas de uno natural. Para el uso y aprovechamiento del recurso hídrico, todo usuario requiere tramitar un premiso de concesión ante la autoridad ambiental competente. No obstan te, toda persona puede usar las aguas de uso publico sin esta autorización si es para beber, bañarse o lavar ropa y/o otros objetos similares que cumplan con las normas sanitarias sobre la materia y con las de protección de recursos naturales. Esto, lamentablemente, no requiere que se conserven las aguas en estado de pureza o potabilidad.
La concesión de aguas superficiales con siste en tener el derecho al uso del agua para el siguiente fin:
Abastecimiento doméstico en los casos que requiera derivación (…)
El otorgamiento de aguas para satisfacer concesiones está sujeto a la disponibili dad del recurso; por esto, el Estado no puede ser responsable cuando por causas naturales no hay garantía de la cantidad de agua concedida o su calidad.
Derecho al agua limpia
La mejora del suministro de agua es una oportunidad para resolver los problemas de salud. Por lo tanto, esto demuestra la importancia de establecer modelos inte grales de evaluación y gestión para garan tizar calidad. Actualmente, existen numer osas metodologías para detectar la contam inación microbiana del agua. Sin embargo, el alto coste que el tiempo de análisis y el aislamiento en cultivos de microorgan ismos microorganismos, ha sido un obstácu lo para establecer la calidad del agua microbiana del agua para el consumo humano.
La presencia o aumento de bacterias, parásitos, virus y hongos en el agua surge por: Efecto directo o indirecto de cambios en el medio ambiente, urbanización no con trolada, crecimiento industrial, pobreza, disposición inadecuada. Teniendo esto en cuenta, se reitera y reconoce la necesidad de La higiene ambiental, como aspecto del derecho a la salud por el apartado b) del párrafo 2 del artículo 12 del Pacto, que busca la adopción de medidas no discrimi natorias para evitar los riesgos para la salud que representa el agua insalubre y contaminada por sustancias tóxicas.
El derecho al agua 3
Cumbre Mundial sobre el Desarrollo Sostenible, Plan de Aplicación de 2002, párrafo 25 c).
Se considera el reclamo del autor Gómez Orea “que el concepto de ambiente errónea mente se ha asimilado al de medio”, esto establece la clara diferencia entre los dos conceptos, ya que el medio delimita únicamente a factores fisicoquímicos y biológicos, mientras que al ambiente incorpora además factores socioculturales que influyen sobre los mismos aspectos físico-químicos. Por ejemplo, las condi ciones sanitarias han afectado las rela ciones sociales y dinámicas de poder que surgen alrededor del eje ambiental.
Renovación urbana


Una definición de renovación urbana se resume como:
“Dar cualidades o aspecto modernos de la edificación, equipamientos e infraestruc turas de la ciudad, necesaria a consecuen cia de su envejecimiento o para adaptarla a nuevos usos y actividades demandadas (…)”
Sin embargo, la renovación muchas veces puede pasar por alto el impacto ambiental que causa el entorno construido a su alre dedor, al igual que lo que representa el incremento poblacional de un sector urbano. Asimismo, también los intereses de una población existente pueden ser ignora dos.
Como dijo María Buenaventura, el eje ambi ental como referente urbano ya no es un río, pero aun así no olvida su cuerpo y curso, aunque lo hayan enterrado y canali zado. Aunque lo desocupen, laven y vuelvan a llenar. Es decir, hay ciertas relaciones que han surgido a través de la renovación urbana de este cuerpo fluvial por el arquitecto Rogelio Salmona, que centraron al rio como epicentro del paisaje de la avenida Jiménez.
Impacto renovación urbana Renovación potencial ecológico Sociedad Colombiana De Arquitectos Bogota

Entorno cientifico
Entender las reacciones y procesos que afectan la calidad del agua, especifica mente aquellas que afectan el uso de jab ones y grasas corporales.
4
RESUMEN
La dureza del agua se define como la suma de concentraciones de compuestos minerales en una determinada cantidad de agua, espe cíficamente las sales que contienen magne sio y calcio. Para determinar la dureza de una muestra se realiza una titulación aña diendo EDTA y un indicador. La medida del punto final del método volumétrico de EDTA, aumenta con el pH sin llegar a una precipitación de carbonato de calcio o hidróxido de magnesio. El valor obtenido, de pH de 10, reveló una solución de orden básico. El valor de la dureza total de la muestra determinó un agua de clasificación dura, esto determinó también la necesidad de un proceso de adición de desinfec tantes.
Palabras clave dureza, alcalinidad, pH.
INTRODUCCIÓN/MARCO TEÓRICO
La dureza es utilizada a menudo por quími cos analíticos como parámetro de medida de ciertos cationes importantes presentes en los cuerpos de agua naturales. Este mide la concentración total de los iones de calcio y magnesio, las dos especias más presentes dentro de la medida de la dureza de agua. Esto se puede definir de la siguiente forma:
Dureza=[Ca^(2+) ]+[Mg^(2+)]
Este valor puede determinarse valorando una muestra problema que contenga ácido etilendiaminotetraacético (EDTA), el cual es una solución que forma complejos con cationes. La dureza es expresada en uni dades de masa en miligramos por litro de carbonato de calcio que contiene la misma cantidad de iones dispositivos (+2).
La mayor parte del calcio que aporta a la dureza proviene del CaCO3 en forma de piedra caliza, la cual entra por medio de depósito mineral del CaSO4. Por otro lado, la parte de magnesio entra en el agua de la dolomita. Es importante tener en cuenta los minerales que son depositados en cuer pos de agua ya que aportan a definir el agua como dura si estas concentraciones de iones de calcio y magnesio son significa tivas. La dureza es un aspecto importante de las aguas natural, ya que estas concen traciones forman sales insolubles con los iones dentro del jabón, formando espuma y nubosidad en el agua limpia. Hay ciertos reglamentos y umbrales que ofrecen el gobierno nacional y la OMS que definen el agua potable como agua con una dureza que oscila entre los 10 y 500 mili gramos. A medida que el agua se acerca a sobrepasar este rango el agua afecta la limpieza en el hogar e incluso su sabor. Esto se debe a que entre más procesos de limpieza y desinfección requiera el agua más sabor va a conseguir; es decir, cuanta más cal se añada al agua mayor sabor se le va a percibir.
La determinación de la dureza en términos de calidad de agua se rige por la cantidad de cationes que forman compuestos insolu bles con sustancias como el jabón. El método más tradicional consiste en titu lación con jabón, a mayor dureza mayor jabón empleado. Sin embargo, en este caso se va a determinar por medio de una titu lación usando el equipo SPARK con EDTA y una muestra problema que contiene magnesio y calcio. El método para los cálculos será medir las concentraciones de los cationes polivalentes en unidades de mg/L de CaCO3. Con estos resultados se va a determinar en qué rango de dureza se encuentra la mues tra estudiada en el laboratorio, por medio de la siguiente clasificación. Tabla 1.1 Clasificación de la dureza según el rango de dureza en mg/L como CaCO3 (Davis and Cornwell 2008)
Rango de Dureza (mg/L) como CaCO3 Descripción
0-75 Blanda 75-100 Moderadamente Dura 100-300 Dura >300 Muy Dura

DESARROLLO EXPERIMENTAL
En la Figura 1-4 se presenta el registro fotográfico del desarrollo experimental llevado a cabo para evaluar el agua del eje ambiental.


De forma resumida, lo que se llevó a cabo es una titulación que determina algunos valores cruciales para el analisis de agua. La muestra se pasa por un filtro de membrana y se mantiene incubada para ver creceer cualquier presencia de microorgan ismos patógenos.

pH 10.21
Alcalinidad 119 Dureza Cálcida 66.31
PREGUNTA DE INVESTIGACIÓN
¿Qué implicaciones tiene el valor de dureza en la calidad y tratamiento de aguas?
La solución metálica descrita en esta cualidad es muchas veces un problema por su capacidad corrosiva, además de que, a pesar de haberse tendido relaciones entre el consumo de magnesio y mejoras en la salud cardiovascular, el consumo de líqui dos en esta condición representa problemas para procesos digestivos al aparecer como factor de variación de los ácidos estoma cales. En el caso particular de magnesio y calcio, el riesgo de envenenamiento es menor y no muy revisado.
Cuando las tuberías están corroídas, parte del metal de la tubería entra en el agua potable y es consumida. Es decir, el prob lema realmente no solo afecta a los habi tantes de calle.
ANÁLISIS DE RESULTADOS
La dureza total refleja un valor dentro del rango de aguas duras. Esto indica que según la OMS y la norma colombiana esta muestra de agua no debería ser considerada como agua potable. Según los cálculos realizados se puede afirmar que los mine rales o ion en este caso que más aporta al valor de dureza de esta solución es el calcio. Esto en términos de tratamiento y ablandamiento del agua implica un menor costo debido a que la remoción de Mg +2 es más costosa que la del Ca 2+ debido a que el pH se debe subir mucho más. Es decir, es mucho más costoso remover la dureza cuando se debe añadir soda, lo cual en este caso no fue necesario.
Esto en términos de aplicación a la vida cotidiana, implica que la dureza reaccione con jabones creando precipitados insolu bles y nubosidad en el agua, lo cual genera problemas de taponamiento de las tuberías.
Rango de Dureza (mg/L) como CaCO3 Descripción 0-75 Blanda 75-100 Moderadamente Dura 100-300 Dura >300 Muy Dura
Química ambiental 6
SUBDIRECCIÓN DE HIDROLOGÍA - GRUPO LABORATORIO DE CALIDAD AMBIENTAL

Entorno social
Reconocer la mayor cantidad de perspectivas de las personaes que recurren en esta zona. Buscar una propuesta que no afecta ni incomode ningu na comunidad que hace uso activo del eje ambiental.
Por medio de observaciones y recolec ción de testimonios se busca entender como esta diseñado el espacio a partir de las prácticas sociales y cultura les. Según el arquiecto jan Gehl, la ciudad se divide en 4 aspectos:
Ciudad Vital se refiere al hecho de que las personas hagan uso del espacio urbano a manera de actividad física, encuentros sociales, propuestas culturales.
Ciudad Segura consiste en que el diseño aumente la densidad de la población que reside y circula en la calle mediante trayectos cortos espacios públicos atrac tivos y variedad de servicios, trasmitiendo la sensación de seguridad al haber mayor número de observadores.
Ciudad sostenible enfatizar en la reducción del uso de recursos mediante sistemas de transporte alternativo.
Ciudad Sana consiste en diseñar espacios que permitan a sus habitantes mejorar su calidad de vida mediante espacios públicos que les permitan desarrollar diferentes actividades físicas reduciendo así el sedentarismo y el estrés.
Para entender mejor estos aspectos y las relacionas sociales dentro de este entorno urbano, se realizaron una seria de entrev istas a personas que no hacen parte de la comunidad estudiantil de la Universidad de los Andes.

“Si en ningún lado les dan oportunidad ni nada, y ven la oportunidad ahí de bañarse pues lo hacen, pero no me incomoda porque considero que también es gente que lo necesitan. También son seres humanos. Es algo natural.”
- Vendedor de Algodón de azúcar
“Pueden encontrar algún sitio más intimo para hacer eso. Acá frecuenta mucho turis ta”
- Reciclador
“No se ven tan seguido cuando hay mucha gente (…) a veces los domingos por la mañana que no hay nadie”
- Reciclador
Entorno simbólico

Por medio de diseños y esquema se busca retratar la controversia de manera simbólica.
el producto de la investigación será una instalación de un tendedero en una porción del eje ambiental, para esto tendremos en cuenta una buena ubicación que no inter rumpa las actividades de tránsito, pero que igual sea visible y llamativo para los transeúntes y habitantes del sector. En este tendedero es donde se colgarán carte les con información sobre el estado del agua, las actividades que desempeñan los actores, se dejará ropa de segunda mano para el uso gratis de los habitantes de calle, será un espacio de socialización entres estudiantes, visitantes locales, turistas, vendedores y residentes. Esto con el fin de crear un espacio amable y que concientice a las personas de mantener un espacio público salubre y amable para sus visitantes.

Nos encaminamos por una línea artística y social que es el tendedero, una herramien ta útil donde se busca generar redes al interior de una actividad, dado que visi biliza cada uno de los perfiles de las personas presentes en un espacio físico determinado, en este caso el río Vicachá, permitiendo que todos puedan acceder y conocer esta comunidad.
Junto con visibilizar, el tendedero per mite proyectar conversaciones futuras y crear relaciones mutuas como son los estudiantes y los habitantes del sector, y es que al tener un espacio para que los participantes puedan dejar sus contactos a personas que no conocían anteriormente, se puede abordar algún trabajo conjunto, establecer alguna reunión, solicitar o entregar información del agua y necesi dades del sector, entre otros.
S T A L A C I O N


Memoria de diseño

El primer esquema que se realizó para ilustrar las primeras ideas de ejecución del tendedero fue un collage. Este mostra ba como base la noticia de habitantes de la calle haciendo uso de un caño para sus necesidades humanos. Asimismo, se repre sentan dentro del collage algunas de las ilustraciones que se usaron en el 2021 por el colectivo EN-Tendedero. Siguiendo este hilo de ideas de como generar un tendede ro, se debatieron distintos estilos que generaban varias funciones. Algunas mas complejas y funcionales y unas más sim bólicas y conceptuales. Mediante el ejer cicio de escoger imágenes para proyectar todo lo que el proyecto discute, se abordaron las ultimas 2 opciones de inter vención. Ambas como forma de instalación artística con el poder de informar e interrumpir el paisaje existente para los estudiantes y demás personas que trascur ren por esa zona.










